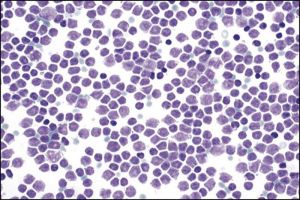
縱隔霍奇金淋巴瘤

疾病描述
 縱隔霍奇金淋巴瘤
縱隔霍奇金淋巴瘤 症狀體徵
 縱隔霍奇金淋巴瘤檢查化驗
縱隔霍奇金淋巴瘤檢查化驗 1.症狀:大約不到10%的原發性縱隔惡性淋巴瘤病人沒有任何症狀,常規體檢和胸部X 線檢查沒有陽性發現。25%的病人有臨床症狀。在結節硬化型中90%有縱隔侵犯表現,可同時伴有頸部淋巴結腫大,受侵犯的淋巴結生長緩慢。其中50%的病人僅有縱隔占位的症狀,他們大部分為婦女,年齡在20~35 歲。病人表現為局部症狀,局部症狀如胸部疼痛(胸骨,肩胛骨,肩部,有時與呼吸無關),緊束感, 咳嗽(通常無痰),呼吸困難,聲音嘶啞,為局部壓迫所引起。有時也會出現一些嚴重的症狀如上腔靜脈綜合徵,但十分罕見,縱隔霍奇金病如侵犯肺、 支氣管、 胸膜,可出現類似 肺炎的表現和胸腔積液,部分病人還有一些與淋巴瘤相關的全身表現如:
縱隔霍奇金淋巴瘤
縱隔霍奇金淋巴瘤 (2)乙醇疼痛:17%~20%的霍奇金病病人在飲酒後20min,病變局部出現疼痛。其症狀可早於其他症狀及X 線表現,具有一定的診斷意義。當病變緩解或消失後,乙醇疼痛即行消失,復發時又可重現,機制不明。
2.體徵:常見的體徵包括胸骨和胸壁變形可伴有靜脈擴張(不常見),可觸及乳內淋巴結腫大(不常見),氣管移位,上腔靜脈梗阻,喘鳴,喘息,肺不張和實變,胸腔積液和心包積液的體徵。聲帶麻痹、Horner 綜合徵及臂叢神經症狀不常見。同時應檢查淺表淋巴結有無腫大。
疾病病因
霍奇金病與下面幾個因素有關:①遺傳學異常:②病毒感染。
診斷檢查
 縱隔霍奇金淋巴瘤診斷要點
縱隔霍奇金淋巴瘤診斷要點 實驗室檢查:常有輕或中度貧血,10%屬小細胞低色素性貧血。 白細胞多數正常,少數輕度或明顯增多,伴中性粒細胞增加。除血常規外, 紅細胞沉降速率也是主要的檢查指標,因為血沉可以指導預後。肝腎功能, 血清免疫球蛋白的檢查可以評價全身情況。
其他輔助檢查:
1.X 線檢查 胸部X 線檢查為重要的常規檢查。從目前資料分析縱隔淋巴瘤沒有明確的診斷性放射學特徵。但或多或少可以輔助診斷。霍奇金淋巴瘤以上縱隔和肺門淋巴結對稱性融合呈波浪狀凸入肺野、淋巴結間界限不清為典型改變,累及氣管分叉和肺門淋巴結較氣管旁淋巴結為多。侵犯前縱隔和胸骨後淋巴結是霍奇金淋巴瘤又一特徵性X 線表現。 霍奇金淋巴瘤總是先有縱隔和肺門淋巴結病變,然後出現肺內病變。肺內特徵性表現為呈光芒放射狀的索條影,可能與肺內淋巴管向肺門引流受阻有關。霍奇金淋巴瘤可出現胸腔積液,但胸腔積液作為惟一的X 線表現罕見。如 腫瘤巨大會造成周圍器官及組織壓迫,導致上腔靜脈梗阻,氣管移位,肺不張,並侵入胸壁、胸骨和(或)胸壁同時受侵犯。可以是腫瘤直接侵犯也可以是乳內淋巴結腫大侵犯所致,為重要放射學表現。腫瘤經乳內淋巴鏈轉移可侵犯肋間淋巴結,並在脊柱旁形成腫塊。同時 胸壁淋巴結轉移或心包受累可導致一側心包旁淋巴結,膈肌淋巴結和(或)膈肌受侵犯。上述表現雖不是霍奇金淋巴瘤特異性表現,但對診斷及制定治療方案很有意義。
2.CT 掃描 有學者複習診斷明確的霍奇金淋巴瘤CT 片後發現70%的病人有胸部侵犯,一般腫塊邊緣不規則密度不均,有時腫瘤包繞血管,並向四周縱隔浸潤。它向外侵犯方式為向心性表現,即從前縱隔或旁縱隔的淋巴結向四周淋巴結侵犯,然後到肺門區隆突下,橫膈組和乳內淋巴結,極少累及後縱隔淋巴結。肺轉移為後繼表現並可侵犯胸膜、心包和胸壁,表現為 胸腔積液,心包積液。胸壁受侵常為前縱隔和乳內淋巴結病變向胸壁蔓延,沒有胸內淋巴結受侵而腋淋巴結受侵者少見。
3.創傷性活檢
(1)經皮穿刺活檢:經皮穿刺活檢是有較長歷史的一種診斷方法。穿刺活檢針分為兩類:①抽吸針:針細柔韌性好,對組織損傷小,併發症少。②切割針:針較粗,對組織損傷大,併發症較多。一般而論,應提倡22 號針穿刺,20~22號針稱為安全針,屬於 細胞學檢查。18 號針穿刺可取得較多的組織細胞,但併發症多,危險性大,18 號針穿刺活檢屬於病理組織學檢查。根據不同的部位可用抽吸或切割法分別施行。抽吸是當針尖達到病變區內後將針芯取出,與30ml空針管相接,向上提針塞利於壓力作用形成真空狀態,做數次快速來回穿刺:針尖移動範圍不能>0.5~1cm,呈扇形,使穿刺區抽吸的細胞組織進入針管中,將針管中的組織細胞做塗片,放到無水乙醇的器皿中固定,立即染色看塗片,明確是否真正抽吸到細胞組織,否則需重做抽吸。然後拉緊注射器針塞連同穿刺針和注射器一同拔除。切割法一般由套管,切割針頭和針芯組成。在CT 和B 超引導下刺入合適的位置,將切割針頭和針芯向前推進0.5~1cm,拔出針芯,回拉並鏇轉切割針頭,切取部分組織後再將針頭和套管一起拔出。穿刺後再在同一部位做CT 或B 超檢測,觀察有無異常改變。穿刺術後嚴密觀察2~4h。
(2)縱隔鏡檢查:分為頸部縱隔鏡檢查,前縱隔鏡檢查,後縱隔鏡檢查。一般套用頸部及前縱隔鏡檢查兩種標準的探查手術方式。頸部縱隔鏡檢查指征是氣管旁腫物和縱隔淋巴結活檢,以後者套用較多。潛在的危險是損傷大血管及左喉返神經損傷。前縱隔鏡檢查主要用於主肺動脈窗淋巴結或腫塊活檢。較常見的併發症為氣胸。具體方法見本書相關章節。
(3) 頸部淋巴結切除術:頸部淋巴結,有 頦下淋巴結群、頜下淋巴結群和頸淋巴結群等幾組。對於性質不明的淋巴結腫大,或可疑的淋巴結區域須做病理組織學檢查以明確診斷。切口應根據病變部位選擇,術中注意淋巴結周圍多為 神經、血管等重要組織,術中應做細緻的鈍性分離,以免損傷。鎖骨上淋巴結切除時,應注意勿損傷臂叢神經和鎖骨下 靜脈,還要避免損傷胸導管和右 淋巴導管,以免形成乳糜胸。
臨床分期
霍奇金淋巴瘤的病變範圍採用Ann Arbor分期系統:Ⅰ期 病變限於1個淋巴結區或單個結外器官(IE)受累。
Ⅱ期 病變累及橫膈同側兩個或更多的淋巴結區,或病變局限侵犯淋巴結外器官及橫膈同側一個以上淋巴結區(IIE)。
Ⅲ期 橫膈上下均有淋巴結病變。可伴脾累及(ⅢS)、結外器官局限受累(ⅢE),或脾與局限性結外器官受累(ⅢSE)。
Ⅳ期 一個或多個結外器官受到廣泛性播散性侵犯,伴或不伴淋巴結腫大。肝或骨髓只要受到累及均屬Ⅳ期。
V期 各期進一步分組:
A- 無全身症狀。
B- 有全身症狀:不明原因的發熱(>38℃)、盜汗、6個月內體重下降>10%。
E- 由一個淋巴結部位局部擴散引起的單一結外部位受累。
X- 塊型:在T6—T7水平縱隔寬度大於胸腔直徑的三分之一,或腫塊最大直徑>10cm。
鑑別診斷
 縱隔霍奇金淋巴瘤
縱隔霍奇金淋巴瘤 2.胸內巨大淋巴結增生 是一種罕見的,病變局限於腫大的淋巴結的原因不明的良性病變,又稱為Castleman 病、縱隔淋巴結樣錯構或血管濾泡樣淋巴結增生。本病可沿淋巴鏈發生於任何部位,但70%見於縱隔,其次為肺門區肺血管水平。發病年齡為50~70 歲。根據胸內巨大淋巴結增生的組織學表現分為3 型: ①透明血管型;②漿細胞型;③混合型。本病一度被認為是異位胸腺增生和胸腺瘤,這種看法被否定。病人多為40~50 歲的青壯年,發病無性別差異。本病無侵襲性,亦不發生遠處轉移。90%的病人無症狀,在常規體檢和出現胸內器官結構的壓迫症狀後,經胸部X 線發現。有部分病人伴有貧血、乏力、關節疼痛、盜汗和低熱等全身症狀。手術切除病變後症狀消失。X 線檢查胸內巨大淋巴結增生可發生於縱隔的任一區域以及肺門和肺實質內。腫塊可位於胸腔中線的一側或兩側,X 線表現無特異性。 CT 掃描和主動脈造影有一定的診斷價值。血管造影可顯示腫塊的滋養血管和發生部位。其滋養動脈顯示較為清晰,但引流靜脈顯影不清楚。治療以外科治療為主併發症很少,療效滿意,術後不易復發。
3. 中央型肺癌 病人一般年齡較大,可有長期吸菸史,無任何誘因出現咳嗽、咯血和 痰血,同時伴有胸痛、胸悶、氣急等臨床症狀。放射學影像發現肺門及縱隔有占位性病變。肺門腫塊被認為是中央型肺癌最直接、最主要的影像學表現。肺門腫塊表現為結節狀,邊緣不規則,也可有分葉表現,同時尚可見阻塞性肺炎,肺不張。有些惡性程度高的肺癌腫瘤可迅速侵入支氣管壁伴肺門淋巴結轉移,在受累支氣管明顯狹窄之前往往有明顯占位。中央型肺癌肺門腫塊邊緣有毛刺,並且病變以支氣管為軸心向周圍浸潤。中央型肺癌常同時伴有肺門、縱隔淋巴結腫大,淋巴結腫大與癌組織相融合,包繞周圍血管,神經並對周圍器官造成壓迫。大部分病人經痰脫落細胞檢查及支氣管鏡檢查得到確診。
4. 結節病 縱隔原發性結節病比較少見,一般不容易確診。結節病是一種非乾酪性肉芽腫疾病,溫帶地區較熱帶地區多見,黑色人種的發病率較高,可發現於任何年齡,但多見於20~40 歲。結節病症狀多數較輕,或無症狀,常於體檢胸透時發現肺門淋巴結腫大。表現為肺門腫大的淋巴結大多雙側對稱,多結節粘連可呈分葉狀,邊緣光滑銳利,常伴有氣管旁,主-肺動脈窗,隆突下淋巴結腫大及肺部表現,兩肺紋理增多,粗索條狀,網狀,小結節狀腫塊:結節病並胸內淋巴結腫大一個特點是一般不壓迫上腔靜脈及其他大血管。淋巴結可發生鈣化,呈蛋殼樣。手術切除效果良好。
治療方案
 縱隔霍奇金淋巴瘤
縱隔霍奇金淋巴瘤 1.手術原則 原發性縱隔淋巴瘤病人的治療結果相差很大,主要的問題是沒有和缺乏足夠資料來明確診斷,同時由於各亞型之間治療與未治療的情況缺乏合理分析造成病人治療的結果出入很大。手術不是治療霍奇金淋巴瘤的必要手段,而且完整切除也是不可能的。外科醫師的主要任務是提供足夠診斷的組織標本以幫助病理分期,通過 影像學檢查對已經明確病變範圍的腫塊採取適宜的手術方法獲取足夠材料以更好的明確診斷。
2.手術方法 外科醫師根據影像學顯示腫瘤的部位和範圍來決定具體的手術方法。一般有以下幾種:縱隔鏡縱隔切開術、胸骨上部分切開術、胸骨正中切開術、後外側標準開胸術。一般來說,通過活檢鉗所獲取的標本較小,很難取得高質量和有病理價值的材料。使病理科醫師難以診斷,而且組織太少也無法進行諸如免疫化學、流式細胞儀分析、電鏡檢查等進一步診斷。對反覆穿刺還診斷不明的占位病變可施行縱隔切開一類有創手術。無論採取什麼方法,在取得標本後應快速病理切片以明確診斷。外科醫師根據病理科醫師的意見,決定所獲標本是否滿意,如果可以取得明確診斷則不需要重複活檢,以減少併發症及所造成的延誤治療等問題。除了進行活檢之外,外科手術還可以了解縱隔受累情況,並能在手術野內對可疑之處進行活檢。因此,對選擇最佳治療方法以及幫助確定放療範圍具有極大價值。由於切除部分腫瘤並不增加併發症,在必要的時候可擴大切除範圍,但要注意檢查和活檢有引起胸內(肺、心包、胸壁、 乳內淋巴結、 膈肌)播散的可能性。
 放射治療
放射治療 4. 放射治療 照射方法分3 種:局部照射、不全淋巴結照射及全淋巴結照射。不全淋巴結照射包括受累淋巴結及腫瘤組織外,尚需包括附近可能侵及的淋巴結區。例如病變在橫膈上採用“斗篷”式,“斗篷”式照射部位包括兩側乳突端至鎖骨上下、腋下、肺門、縱隔以至橫膈的淋巴結,但要保護肱股頭、喉部及肺部免受照射。劑量為35~40Gy,3~4 周為1 療程。霍奇金病IA、IB、ⅡA、ⅡB 及ⅢA 期首先使用放療較合適。IA 期病人如原發病變在膈上,可只用“斗篷”野照射;IB、ⅡA、ⅡB 及ⅢA 期病人均須用全淋巴結區照射。臨床資料證明療效較好。
5.化療 最常用MOPP [氮芥,長春新鹼, 丙卡巴肼(甲基苄肼), 潑尼松(強的松)]方案,晚期霍奇金病的預後已大有改觀。初治者的完全緩解率由65%增至85%。MOPP 至少用6 個療程,或一直用至完全緩解,再額外給2 個療程。霍奇金病對MOPP 有耐藥性,加之MOPP 方案中的氮芥可引起嚴重的靜脈炎和嘔吐,所以文獻推薦了不同的治療方案,其中以ABVD [ 阿黴素, 博來黴素, 硫酸長春鹼(長春花鹼), 達卡巴嗪(甲氮咪胺)]方案較成熟,該方案的緩解率為62%,其對結節硬化型的療效不亞於MOPP。另一優點是方案中無烷化劑。也有採用在MOPP 基礎上加博來黴素和阿黴素。ⅢB 及Ⅳ期病人使用上述聯合化療方案後,最好對原有明顯腫瘤的原發部位,局部加用25~30Gy 放射治療。
預後及預防
預後:國際上霍奇金淋巴瘤的治療策略逐步有所改變,逐漸趨向於以全身化療為主的放、化療綜合治療。聯合化療可取得相應的治療療效,準確的分期診斷已不像以往那么重要。且預後明顯改善。
流行病學
10 歲以下發病少見;10 歲以後發病率顯著上升;20 歲達高峰以後又逐漸下降,至45 歲;45 歲以後霍奇金淋巴瘤發病率隨年齡增長而穩定上升,達到另一高峰。第一高峰在中國和日本不明顯,可能與其結節硬化型發病率低有關。
飲食要點
1、在烹調時多用蒸,煮,燉,儘量少吃油炸,油煎食物。2、要排除毒素。不吃酸漬,鹽醃,霉變,煙燻,色素,香精。不喝烈性酒,最好不沾酒。
3、多吃天然,野生食物,少吃人工複製和精加工的食品;
4、合理進補能提高免疫力。某些滋補品如人參,白木耳,紅棗等有直接或間接抑癌與強身的功效;
5、飲食要平衡,不偏食,不忌食,葷素搭配,粗細搭配,食物品種越多越好;
惡性淋巴癌患者的飲食禁忌?長期的飲食結構,生活習慣等因素造成體質過度酸化,人體整體的機能迅速下降,引起腎虛,肝腎同源,腎虛肝亦虛,進而引起身體代謝循環變慢,血氣凝滯,身體產生大量的酸性垃圾。這時一些內源性疾病就會出現,大量酸性垃圾在淋巴組織細胞系統里堆積,這時淋巴細胞就會癌變。
因為身體組織液酸化,故此淋巴組織細胞處於酸性體液中,進而形成淋巴組織細胞溶氧量下降,造成細胞的活性下降,代謝循環減慢,下降到正常值的65%時,正常細胞就無法生存,但也有不惜改變染色體採取主動變異的細胞,細胞的表型發生改變,腫瘤性狀得以表達,這些細胞迅速擴增,從而形成真正的腫瘤實體。
參考資料
[1] 用藥安全網 http://www.yongyao.net/jbhtml/zghqjlbl.htm
